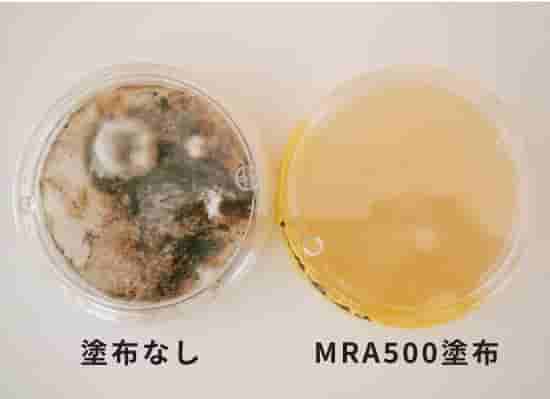
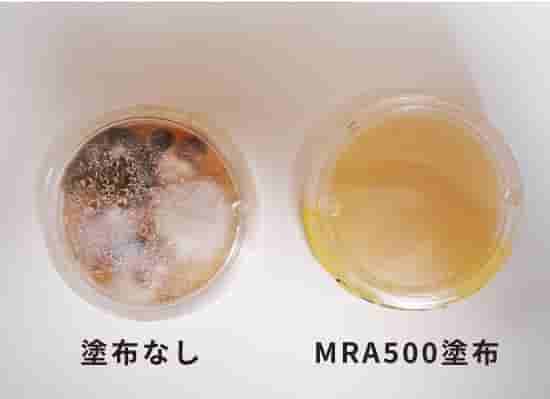

防カビ工事
弊社の防カビ施工は、非常に効果が高く、食品工場など衛生管理に厳しいお客様に支持いただいております
建築物などの内外装などにご利用いただけます。
塗装以外の防カビ工事(内装クロスやカビの繁殖が懸念される
木材・コンクリートなど)にも対応しております。
弊社の防カビ工事4つの特長
対応菌数が多い
建築物などから頻繁に検出される57種類(世界微生物災害防止学会確認)のカビ・菌に全て効果があります
JIS規格(JIS Z 2911)では、指定された10菌の試験菌に対して有効であれば、規格準拠の防カビ剤として認定されます。クロスのりに関しては、指定3菌に効果があれば、JIS規格(JIS A 6922)準拠の防カビ・クロス糊として認定されるのが現状です。
MRA500はこの57菌はもちろん、その他含め商品名のとおり500菌に効果があることが確認されています。(新しい菌が発見されれば都度、効果試験をしているので現在対応菌数は増え続けています。現在では668種類以上。)
MRA500シリーズは、株式会社アメニティーズフォーユーの商品です。安全性が高い
環境ホルモンを一切使用していません
食品ではないので食べることはできませんが、安全性はカフェインの10倍、食塩の4倍と確認されています。【(財)日本食品分析センター:マウスを使った急性経口毒性試験】
世界一厳しいといわれているアメリカのEPA(米環境保護庁)の安全性認定№を取得していて、その認可されているものだけを使用した複合合成の防カビ薬剤です。
効果が持続する
JISより厳しい検査方法で5年以上カビが発生しません。
溶出や蒸発が起こらず、薬剤がその場に留まっていられるためです。
他の一般的な防カビ剤は溶出や気化によって効果を発揮するため、水分の多い場所では効果が持続できず、その後に繁殖するカビは使用前より酷くなります。また、MRA500は有機変化が起こらないため環境に左右されにくくなっています。(熱、紫外線、酸、アルカリ、有機溶剤などによってほとんど分解しません)このふたつの性能により効力が低下していくこともありません。
耐性菌が発生しにくい
複合型の薬剤による兵糧攻め効果によってジワジワと効いていきます。
ひとつの薬剤に対して耐性菌が発生しても複合型のため他の成分が効能するためです。
施工内容
- 塗装工事
- クロスほか
内装工事 - 防水工事
シーリング工事 - くん煙処理工事
- 殺菌メンテナンス材の販売